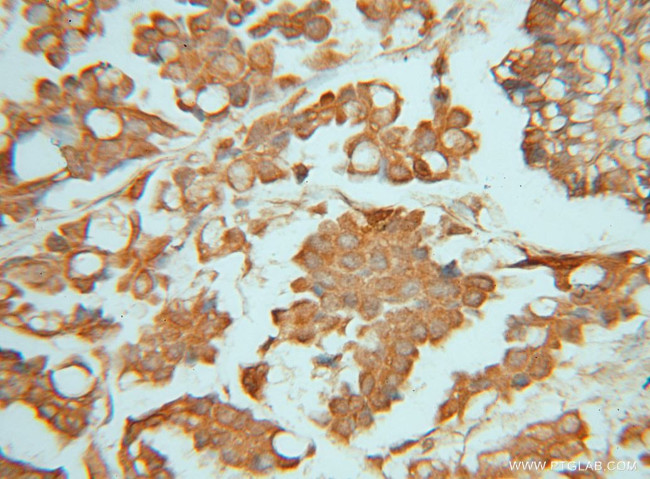
PIGK Antibody in Immunohistochemistry (Paraffin) (IHC (P))

Search
Proteintech
PIGK Polyclonal Antibody
{{$productOrderCtrl.translations['antibody.pdp.commerceCard.promotion.promotions']}}
{{$productOrderCtrl.translations['antibody.pdp.commerceCard.promotion.viewpromo']}}
{{$productOrderCtrl.translations['antibody.pdp.commerceCard.promotion.promocode']}}: {{promo.promoCode}} {{promo.promoTitle}} {{promo.promoDescription}}. {{$productOrderCtrl.translations['antibody.pdp.commerceCard.promotion.learnmore']}}
产品信息
15151-1-AP
种属反应
宿主/亚型
分类
类型
抗原
偶联物
形式
浓度
规格
纯化类型
保存液
内含物
保存条件
运输条件
产品详细信息
Immunogen sequence: MAVTDSLSR AATVLATVLL LSFGSVAASH IEDQAEQFFR SGHTNNWAVL VCTSRFWFNY RHVANTLSVY RSVKRLGIPD SHIVLMLADD MACNPRNPKP ATVFSHKNME LNVYGDDVEV DYRSYEVTVE NFLRVLTGGI PPSTPRSKRL LSDDRSNILI YMTGHGGNGF LKFQDSEEIT NIELADAFEQ MWQKRRYNEL LFIIDTCQGA SMYERFYSPN IMALASSQVG EDSLSHQPDP AIGVHLMDRY TFYVLEFLEE INPASQTNMN DLFQVCPKSL CVSTPGHRTD LFQRDPKNVL ITDFFGSVRK VEITTETIKL QQDSEIMESR YSS (1-332 aa encoded by BC026186)
靶标信息
This gene encodes a member of the cysteine protease family C13 that is involved in glycosylphosphatidylinositol (GPI)-anchor biosynthesis. The GPI-anchor is a glycolipid found on many blood cells and serves to anchor proteins to the cell surface. This protein is a member of the multisubunit enzyme, GPI transamidase and is thought to be its enzymatic component. GPI transamidase mediates GPI anchoring in the endoplasmic reticulum, by catalyzing the transfer of fully assembled GPI units to proteins.
仅用于科研。不用于诊断过程。未经明确授权不得转售。
生物信息学
蛋白别名: GPI transamidase subunit; GPI-anchor transamidase; GPI-anchor transamidase component PIGK, catalytic subunit; GPI8; GPI8 homolog; hGPI8; phosphatidylinositol glycan, class K; Phosphatidylinositol-glycan biosynthesis class K protein; PIG-K; unnamed protein product
基因别名: GPI8; NEDHCAS; PIGK
UniProt ID: (Human) Q92643
Entrez Gene ID: (Human) 10026